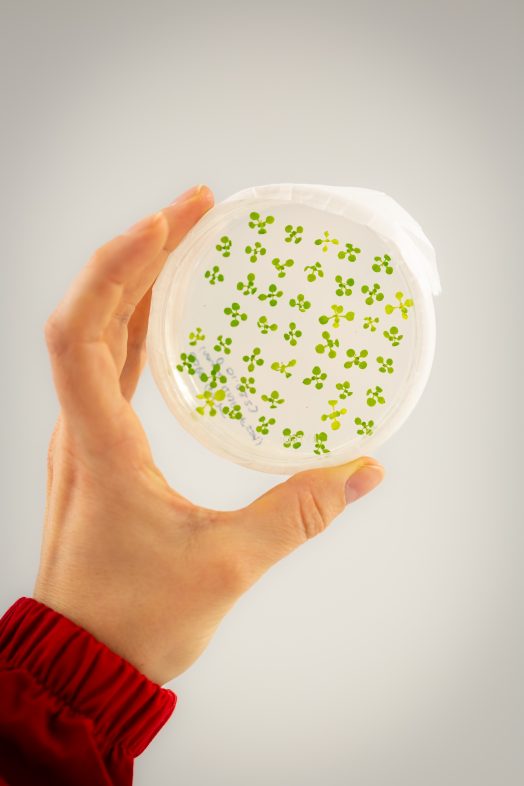

The Plants platform provides equipment and consumables for growing plants for research teams.This platform is located on the 2nd floor and has an S2 containment level.
Missions
The missions of this platform are:
- Ensure the proper functioning of cultivation equipment
- Monitor the phytosanitary state of the plants and carry out a treatment if necessary, preferably in Integrated Biological Protection
- Ensure the availability of equipment and consumables necessary for the cultivation and maintenance of plants
Equipment:
- 4 Aralab 23000L culture chambers
- 1 Aralab 5000L for in vitro culture
- 5 Sanyo culture chambers
- 3 Percival culture chambers
- 1 fluorescent binocular loupe
- 2 horizontal laminar flow hoods